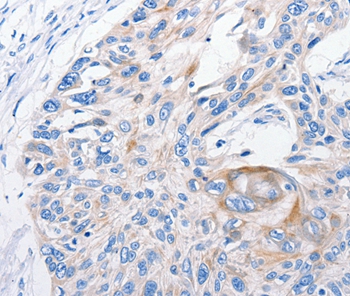

Goat anti-FANCF Antibody
EB06112
ApplicationsWestern Blot, ELISA
Product group Antibodies
ReactivityHuman
TargetFANCF
Overview
- SupplierEverest Biotech
- Product NameGoat anti-FANCF Antibody
- Delivery Days Customer5
- Application Supplier NotePurchase the +ve control! The transfected lysate used to QC this product is available for sale. Please email sales@everestbiotech.com to request datasheet, pricing and delivery information.
- ApplicationsWestern Blot, ELISA
- Applications SupplierPep-ELISA, WB-Trf
- CertificationResearch Use Only
- ClonalityPolyclonal
- Concentration0.5 mg/ml
- Gene ID2188
- Target nameFANCF
- Target descriptionFA complementation group F
- Target synonymsFAF, Fanconi anemia group F protein, Fanconi anemia complementation group F
- HostGoat
- Scientific DescriptionRefSeq number(s): NP_073562. Purification: Antigen affinity purified. Names and symbols: FANCF; Fanconi anemia, complementation group F; FAF
- ReactivityHuman
- Reactivity SupplierHuman
- Storage Instruction-20°C
- UNSPSC12352203